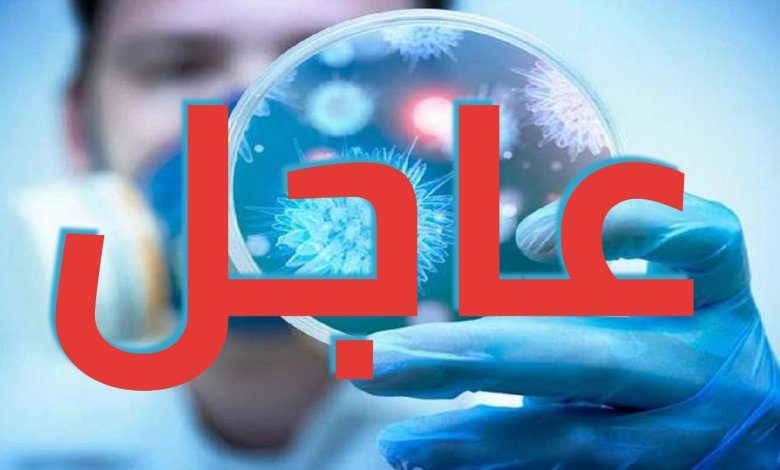

عاجل/ تسجيل 1 اصابة جديدة بفيروس كورونا في تونس ليصبح العدد الجملي 1045 حالة.. التفاصيل
بـــــــــــــــــــــــــــــــلاغ
الوضع الوبائي اليومي لفيروس الكورونا COVID-19 بتونس
تعلم وزارة الصحة أنه بتاريخ 20 ماي 2020، تمّ إجراء 1234 تحليلا مخبريا (المخبر المرجعي بمستشفى شارل نيكول: 38 تحليلا، مخبر معهد باستور تونس: 142 تحليلا، مخبر مستشفى فطومة بورقيبة بالمنستير: 187 تحليلا، مخبر مستشفى فرحات حشاد بسوسة: 96 تحليلا، مخبر مستشفى الحبيب بورقيبة بصفاقس: 129 تحليلا، مخبر المستشفى العسكري: 642 تحليلا)، من بينها 66 تحليلا في إطار متابعة المرضى السابقين ليبلغ بذلك العدد الجملي للتحاليل 43723.
وقد تم تسجيل 07 تحاليل إيجابية، 06 منها لحالات إصابة سابقة لا تزال حاملة للفيروس و01 حالة إصابة جديدة محلية ليصبح العدد الجملي للمصابين بهذا الفيروس، وذلك بعد التثبت من المعطيات وتحيينها، 1045 حالة موزعة كالآتي: 862 حالة شفاء و47 حالة وفاة و136 حالة إصابة لا زالت حاملة للفيروس وهي بصدد المتابعة من بينها 3 مقيمين حاليا في المستشفيات.




